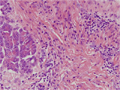

- 11.Gallbladder, Pancreas
- (5)Chronic pancreatitis
Microscopic image(HE stain, low power): Advanced fibrosis is seen within the pancreatic parenchyma and interlobular spaces. Lymphoid follicles are seen forming amongst the fibrosis (arrows).
Click the image to see the enlarged image.